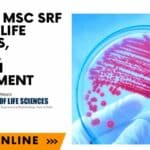
Govt ILS MSc SRF Job For Life Sciences, Biotech, Biochem Recruitment, Apply Online ILS SRF Post 2022

Home Search
microbiology - search results
If you're not happy with the results, please do another search
SGPGIMS Research Assistant Job For MSc & BTech Candidates, Applications Invited
SGPGIMS Research Assistant Vacancy For MSc & BTech Candidates
SGPGIMS Research Assistant Vacancy For MSc & BTech Candidates. SGPGIMS is recruiting candidates for a research...
Calcutta University Dept of Biochem JRF Job For Biotech, Biochem, Biophysics
Calcutta University JRF Opening For Biotech, Biochem, Biophysics
Calcutta University JRF Opening For Biotech, Biochem, Biophysics. JRF Job opening at Calcutta University. Interested and eligible...
ACTREC BTech, MTech & MSc Biotech, Life Sciences Scientific Assistant Recruitment
ACTREC Scientific Assistant Opening For BTech, MSc & MTech Candidates
ACTREC Scientific Assistant Opening For BTech, MSc & MTech Candidates. MSc, BTech and MTech Biotechnology,...
Biotecnika Times Newsletter 21.11.2022 CDRI Jobs, NCCS Admission, Summer Academies Fellowship
Biotecnika Times Newsletter 21.11.2022 CDRI Jobs, NCCS Admission, Summer Academies Fellowship
CSIR-CDRI BTech, MSc Biotech, Life Sciences Project Jobs - Attend Walk-In
CSIR-CDRI Project Jobs 2022...
R&D Job at Bharat Serums and Vaccines For BSc & MSc, Apply Online
R&D Job at Bharat Serums and Vaccines For BSc & MSc, Apply Online
R&D Job at Bharat Serums and Vaccines For BSc & MSc, Apply...
Pepsico R&D Scientist Recruitment – Food Science Job Opening
Pepsico R&D Scientist Recruitment - Food Science Job Opening
Pepsico R&D Scientist Recruitment - Food Science Job Opening. Interested and eligible candidates can check the...
CSIR-CDRI BTech, MSc Biotech, Life Sciences Project Jobs – Attend Walk-In
CSIR-CDRI Project Jobs 2022 For BTech, MSc Life Sciences
CSIR-CDRI Project Jobs 2022 For BTech, MSc Life Sciences. CSIR-CDRI Project Vacancies 2022. BSc., MSc., BTech...
Biotecnika Times Newsletter 18.11.2022 NDDB Trainee Job, CDFD RSP, BITS Pilani Internship
Biotecnika Times Newsletter 18.11.2022 NDDB Trainee Job, CDFD RSP, BITS Pilani Internship
NDDB Trainee Biotech, Botany, Zoology & Microbiology Job - Freshers Can Apply
NDDB Trainee...
Biotecnika Times Newsletter 17.11.2022 CSIR NET June 2022 Cut off & Rank List Released,...
Biotecnika Times Newsletter 17.11.2022 CSIR NET June 2022 Cut off & Rank List Released, Govt HLL Careers
CSIR NET June 2022 Exam Results & Cut-Off...
Bachelor’s & Master’s Degree In Food Tech, Biochem & Microbio Apply at Mondelez For...
Mondelez Quality Executive Job Opening For Food Tech, Biochem & Microbiology
Mondelez Quality Executive Job Opening For Food Tech, Biochem & Microbiology. Mondelez India Foods...
Presidency University Research Fellow Recruitment For MSc & MTech
Presidency University Research Fellow Recruitment For MSc & MTech
Presidency University Research Fellow Recruitment For MSc & MTech. JRF vacancy. Junior research fellow job opening...
Biotecnika Times Newsletter 16.11.2022 DRDO Job, NABI Openings, L’Oreal, Cipla Hiring
Biotecnika Times Newsletter 16.11.2022 DRDO Job, NABI Openings, L'Oreal, Cipla Hiring
DRDO-INMAS Research Associate Recruitment For Life Sciences, Attend Walk-In
DRDO-INMAS Research Associate Recruitment For Life...
ICMR-National Institute for Pathology PhD Programme Admission 2022-23
ICMR-NIP PhD Programme Admission 2022-23, Apply Online
ICMR-NIP PhD Programme Admission 2022-23, Apply Online. ICMR-National Institute for Pathology PhD Programme Admission 2022-23. Applications Invited For...
Biotecnika Times Newsletter 15.11.2022 Govt Internship With Stipend, DBT-inStem Doctoral Programme 2022
Biotecnika Times Newsletter 15.11.2022 Govt Internship With Stipend, DBT-inStem Doctoral Programme 2022
Govt Food Safety Intern Recruitment With Monthly Stipend of Rs. 10,000 pm, Apply...
Govt ILS MSc SRF Job For Life Sciences, Biotech, Biochem Recruitment, Apply Online
ILS SRF Post 2022 For MSc Life Sciences, Biotech, Biochem
ILS SRF Post 2022 For MSc Life Sciences, Biotech, Biochem. MSc Biotech, Biochem, Life Sciences...